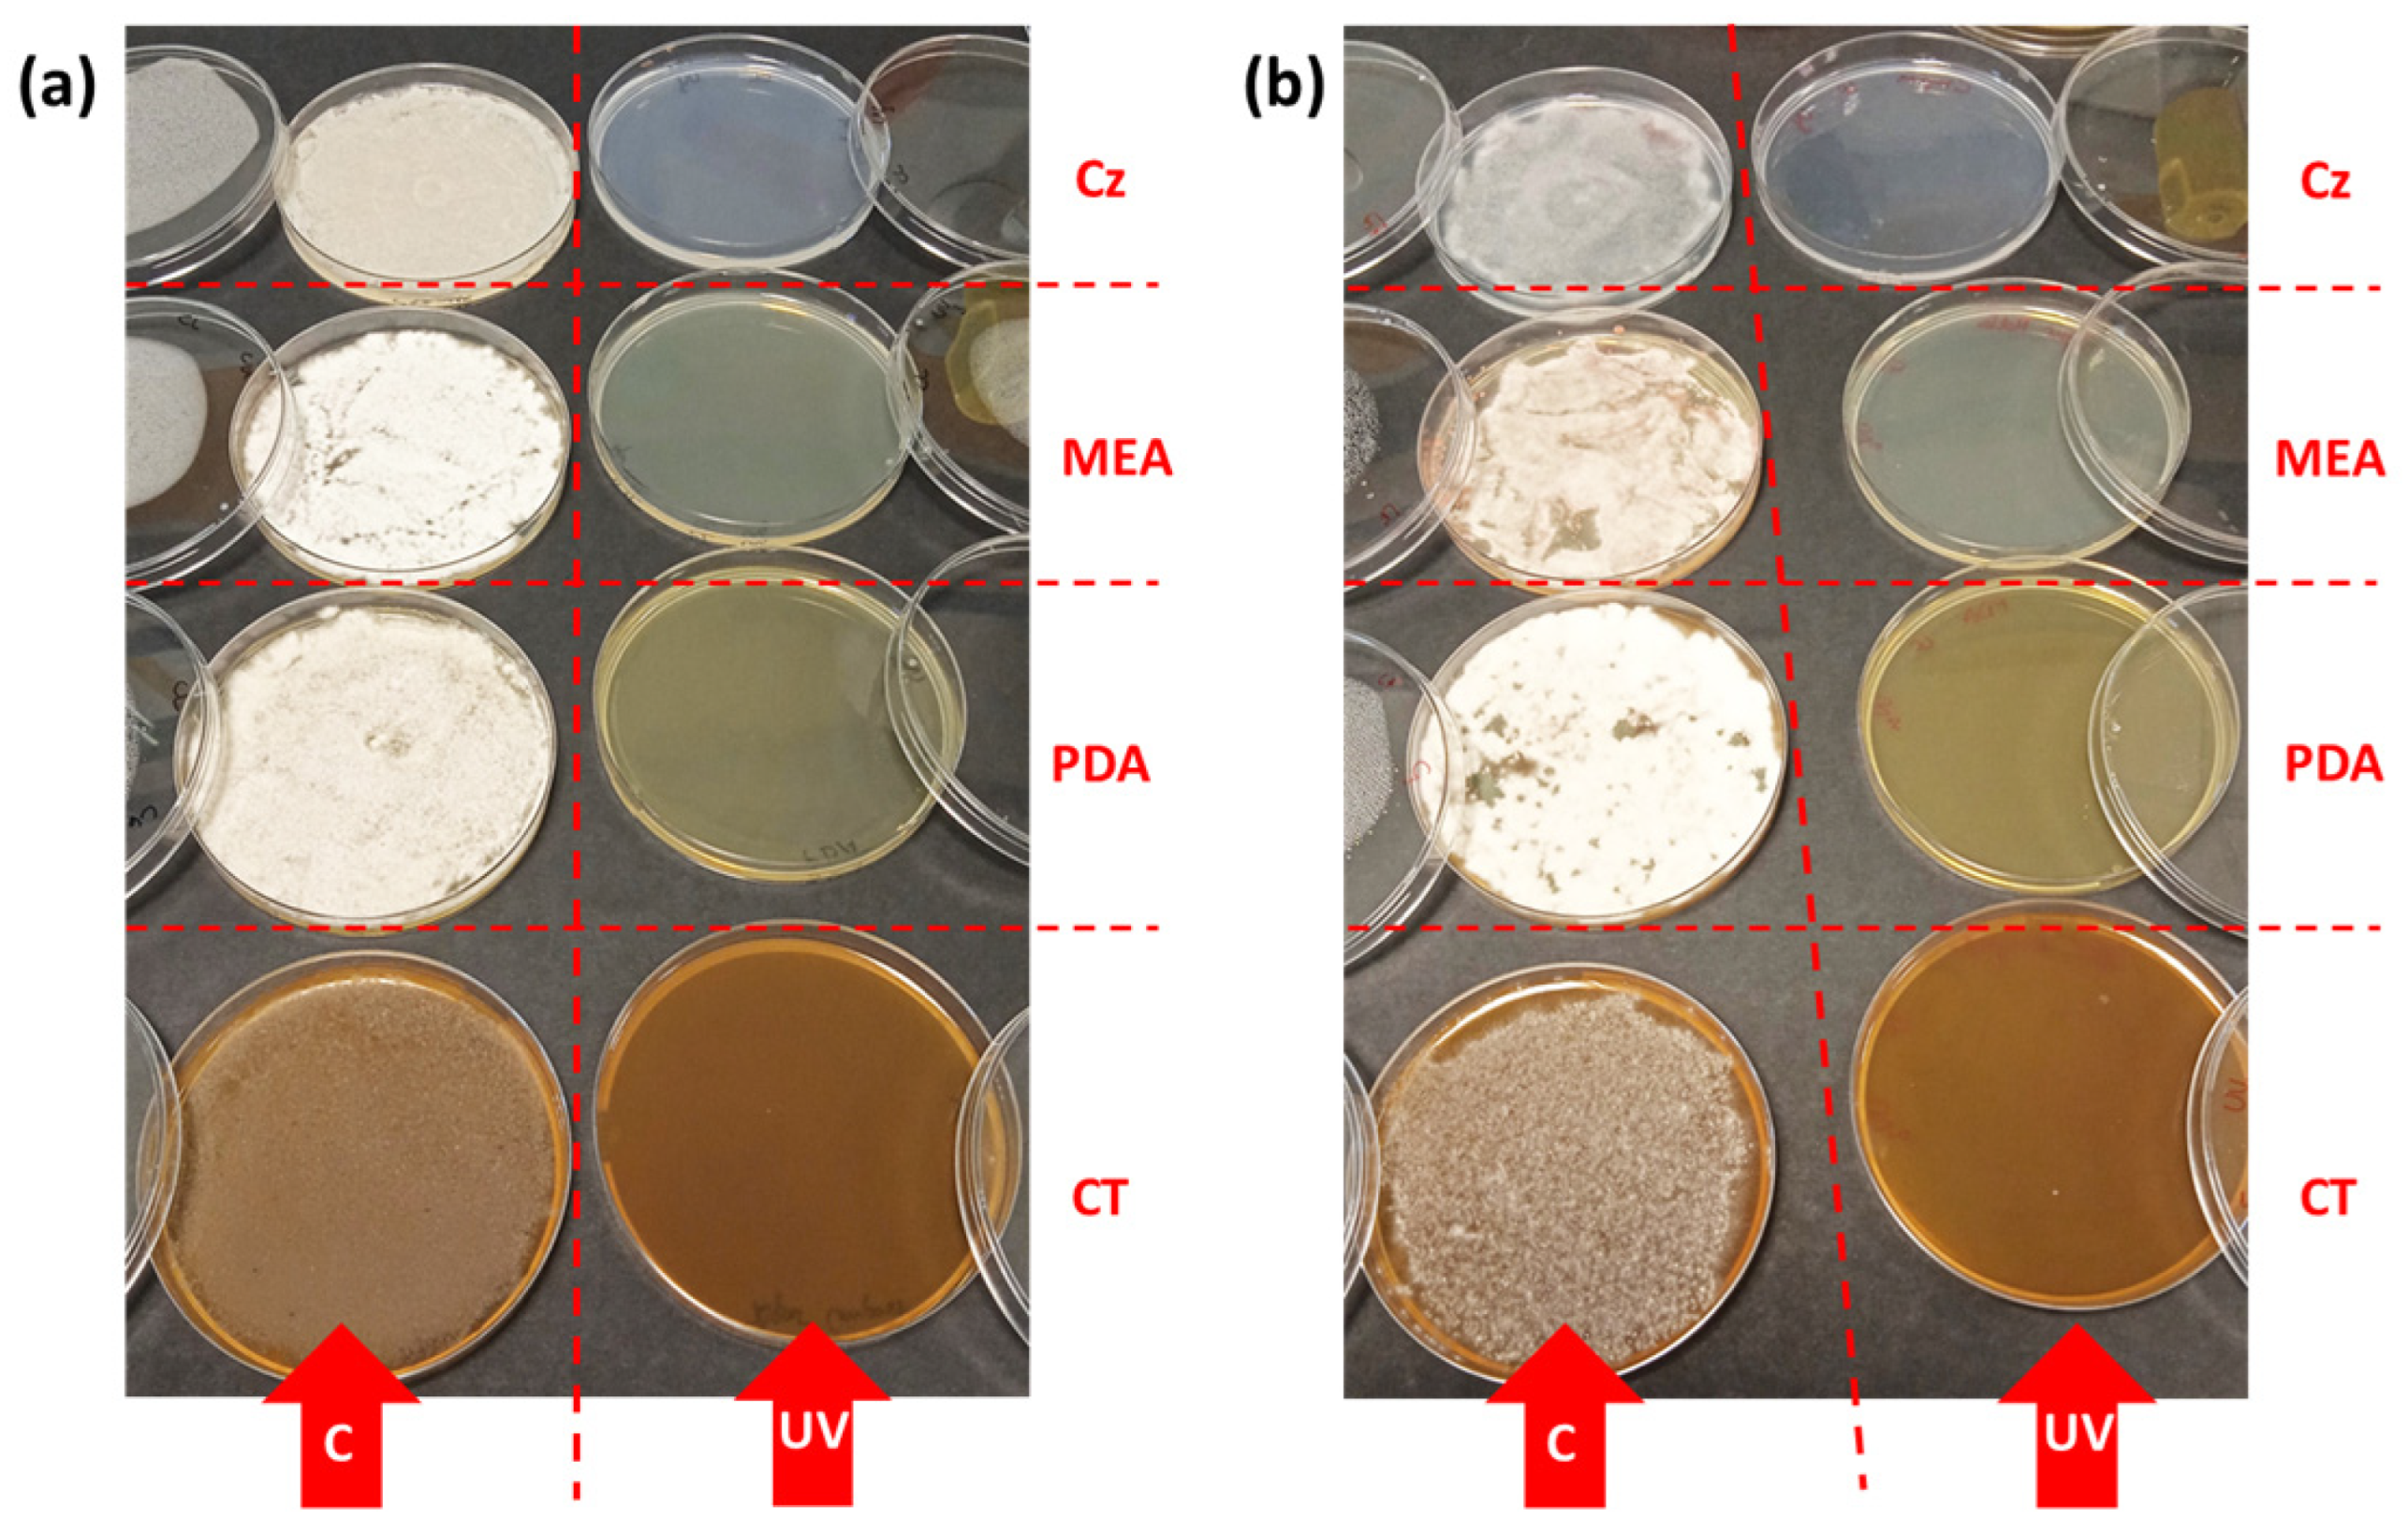
Agriculture 14 00681 g005

The Two Mycological Sides of Ultraviolet-B Radiation: Harmless for Mushroom Mycelia, Harmful for Mycopathogenic Mould Spores
Abstract
1. Introduction
2. Materials and Methods
2.1. Culture Conditions
2.2. Irradiation Conditions
2.3. Analysis of UV-B Effects
2.4. Statistical Analysis
3. Results and Discussion
3.1. Effect of UV-B on the Mycelial Development
3.2. Influence of Culture Media
3.3. Effect on Spore Development
3.4. Effect of UV-B on the Host (Agaricus bisporus) Mycelium
4. Conclusions
Author Contributions
Funding
Data Availability Statement
Acknowledgments
Conflicts of Interest
References
- Fletcher, J.T.; Gaze, R.H. Mushroom Pest and Disease Control: A Colour Handbook, 1st ed.; Manson Publishing Ltd.: London, UK; Academic Press: San Diego, CA, USA, 2008; 192p. [Google Scholar]
- Adie, B.A.T. The Biology and Epidemiology of the Cobweb Disease Pathogen (Cladobotryum spp.) Infecting the Cultivated Mushroom (Agaricus bisporus). Ph.D. Thesis, Imperial College, University of London, London, UK, 2000. [Google Scholar]
- Adie, B.; Grogan, H.; Archer, S.; Mills, P. Temporal and spatial dispersal of Cladobotryum conidia in the controlled environment of a mushroom growing room. Appl. Environ. Microbiol. 2006, 72, 7212–7217. [Google Scholar] [CrossRef]
- Pyck, N.; Grogan, H. Fungal Diseases of Mushrooms and Their Control; Factsheet 04/15, MushTV Publications; AHDB: Warwickshire, UK, 2015; p. 6. Available online: http://horticulture.ahdb.org.uk/mushtv-publications (accessed on 20 January 2024).
- European Commission. Communication from the Commission to the European Parliament, the Council, the European Economic and Social Committee and the Committee of the Regions. “From Farm to Fork” Strategy for a Fair, Healthy and Environmentally-Friendly Food System; European Commission: Brussels, Belgium, 2020. [Google Scholar]
- Agencia Estatal Boletín Oficial del Estado. Real Decreto 1050/2022, De 27 De Diciembre, Por El Que Se Modifica El Real Decreto 1311/2012, De 14 De Septiembre, Que Establece El Marco De Actuación Para Conseguir Un Uso Sostenible De Los Productos Fitosanitarios; Agencia Estatal Boletín Oficial del Estado: Madrid, Spain, 2022.
- Potočnik, I.; Vukojević, J.; Stajić, M.; Rekanović, E.; Stepanović, M.; Milijašević, S.; Todorović, B. Toxicity of biofungicide Timorex 66 EC to Cladobotryum dendroides and Agaricus bisporus. Crop Prot. 2010, 29, 290–294. [Google Scholar] [CrossRef]
- Kosanović, D.; Potočnik, I.; Duduk, B.; Vukojević, J.; Stajić, M.; Rekanović, E.; Milijašević-Marčić, S. Trichoderma species on Agaricus bisporus farms in Serbia and their biocontrol. Ann. Appl. Biol. 2013, 163, 218–230. [Google Scholar] [CrossRef]
- Gea, F.J.; Carrasco, J.; Diánez, F.; Santos, M.; Navarro, M.J. Control of dry bubble disease (Lecanicillium fungicola) in button mushroom (Agaricus bisporus) by spent mushroom substrate tea. Eur. J. Plant Pathol. 2014, 138, 711–720. [Google Scholar] [CrossRef]
- Geösel, A.; Szabó, A.; Akan, O.; Szarvas, J. Effect of essential oils on mycopathogens of Agaricus bisporus. In Proceedings of the 8th International Conference of Mushroom Biology and Mushroom Products, New Delhi, India, 27 November 2014. [Google Scholar]
- Gea, F.J.; Navarro, M.J.; Tello, J.C. Reduced sensitivity of the mushroom pathogen Verticillium fungicola to prochloraz-manganese in vitro. Mycol. Res. 2005, 109, 741–745. [Google Scholar] [CrossRef] [PubMed]
- Grogan, H.M. Fungicide control of mushroom cobweb disease caused by Cladobotryum strains with different benzimidazole resistance profiles. Pest Manag. Sci. 2006, 62, 153–161. [Google Scholar] [CrossRef]
- Usall, J.; Ippolito, A.; Sisquella, M.; Neri, F. Physical treatments to control postharvest diseases of fresh fruits and vegetables. Postharvest Biol. Technol. 2016, 122, 30–40. [Google Scholar] [CrossRef]
- Moody, S.A.; Newsham, K.K.; Ayres, P.G.; Paul, N.D. Variation in the responses of litter and phylloplane fungi to UV-B radiation (290–315 nm). Mycol. Res. 1999, 103, 1469–1477. [Google Scholar] [CrossRef]
- Barnes, P.W.; Robson, T.M.; Zepp, R.G.; Bornman, J.F.; Jansen, M.A.K.; Ossola, R.; Wang, Q.W.; Robinson, S.A.; Foereid, B.; Klekociuk, A.R.; et al. Interactive effects of changes in UV radiation and climate on terrestrial ecosystems, biogeochemical cycles, and feedbacks to the climate system. Photochem. Photobiol. Sci. 2023, 22, 1049–1091. [Google Scholar] [CrossRef]
- Robson, T.M.; Aphalo, P.J.; Banas, A.K.; Barnes, P.W.; Brelsford, C.C.; Jenkins, G.I.; Kotilainen, T.K.; Labuz, J.; Martínez-Abaigar, J.; Morales, L.O.; et al. A perspective on ecologically relevant plant-UV research and its practical application. Photochem. Photobiol. Sci. 2019, 18, 970–988. [Google Scholar] [CrossRef]
- Pescheck, F.; Bilger, W. UV-B Resistance of Plants Grown in Natural Conditions. Annu. Plant Rev. Online 2020, 3, 337–398. [Google Scholar] [CrossRef]
- Hidalgo-Sanz, R.; Del-Castillo-Alonso, M.A.; Monforte, L.; Tomás-Las-Heras, R.; Sanz, S.; Olarte, C.; Pérez-Matute, P.; Íñiguez-Martínez, M.; Ene, A.L.; Martínez-Abaigar, J.; et al. Ultraviolet-B radiation, mushrooms, and vitamin D: From technology to bioavailability. LWT 2023, 186, 115210. [Google Scholar] [CrossRef]
- Zhong, Y.Y.; Dong, S.T.; Cui, Y.; Dong, X.B.; Xu, H.D.; Li, M. Recent Advances in Postharvest Irradiation Preservation Technology of Edible Fungi: A Review. Foods 2023, 12, 103. [Google Scholar] [CrossRef] [PubMed]
- Robson, T.M.; Pieristè, M.; Durand, M.; Kotilainen, T.K.; Aphalo, P.J. The benefits of informed management of sunlight in production greenhouses and polytunnels. Plants People Planet 2022, 4, 314–325. [Google Scholar] [CrossRef]
- Del-Castillo-Alonso, M.A.; Monforte, L.; Tomás-Las-Heras, R.; Martínez-Abaigar, J.; Núñez-Olivera, E. To What Extent Are the Effects of UV Radiation on Grapes Conserved in the Resulting Wines? Plants 2021, 10, 1678. [Google Scholar] [CrossRef] [PubMed]
- Duguay, K.J.; Klironomos, J.N. Direct and indirect effects of enhanced UV-B radiation on the decomposing and competitive abilities of saprobic fungi. Appl. Soil Ecol. 2000, 14, 157–164. [Google Scholar] [CrossRef]
- García Cela, E.; Marín, S.; Sanchís, V.; Crespo-Sempere, A.; Ramos, A.J. Effect of ultraviolet radiation A and B on growth and mycotoxin production by Aspergillus carbonarius and Aspergillus parasiticus in grape and pistachio media. Fungal Biol. 2015, 119, 67–78. [Google Scholar] [CrossRef] [PubMed]
- Yamaga, I.; Kuniga, T.; Aoki, S.; Kato, M.; Kobayashi, Y. Effect of ultraviolet-B irradiation on disease development caused by Penicillium italicum in Satsuma mandarin fruits. Hortic. J. 2016, 85, 86–91. [Google Scholar] [CrossRef]
- Ulevicius, V.; Peclulyte, D.; Lugauskas, A.; Andriejauskiene, A. Field study on changes in viability of airborne fungal propagules exposed to UV radiation. Environ. Toxicol. 2004, 19, 437–441. [Google Scholar] [CrossRef]
- Latorre, B.A.; Rojas, S.; Díaz, G.A.; Chauqui, H. Germicidal effect of UV light on epiphytic fungi isolated from blueberry. Cienc. Investig. Agrar. 2012, 39, 473–480. [Google Scholar] [CrossRef][Green Version]
- Parnell, M.; Burt, P.J.A.; Wilson, K. The influence of exposure to ultraviolet radiation in simulated sunlight on ascospores causing Black Sygatoka disease of banana and plantain. Int. J. Biometeorol. 1998, 42, 22–27. [Google Scholar] [CrossRef]
- Galvao, J.A.H.; Bettiol, W. Effects of UV-B radiation on Lecanicillium spp., biological control agents on the coffee leaf rust pathogen. Trop. Plant Pathol. 2014, 38, 392–400. [Google Scholar] [CrossRef]
- Calonje, M.; García-Mendoza, C.P.; Pérez-Cabo, A.; Bernardo, D.; Novaes-Ledieu, M. Interaction between the mycoparasite Verticillium fungicola and the vegetative mycelial phase of Agaricus bisporus. Mycol. Res. 2000, 104, 988–992. [Google Scholar] [CrossRef]
- Shamsahad, A.; Clift, A.D.; Mansfield, S. Host-parasite interaction between cultivated mushroom, Agaricus bisporus hybrid strain Sylvan A15, and the mycoparasite Verticillium fungicola, a causal agent of dry bubble disease. Aust. Plant Pathol. 2009, 38, 74–78. [Google Scholar] [CrossRef]
- Carrasco, J.; Tello, M.L.; de Toro, M.; Tkacz, A.; Poole, P.; Pérez-Clavijo, M.; Preston, G. Casing microbiome dynamics during button mushroom cultivation: Implications for dry and wet bubble diseases. Microbiology 2019, 165, 611–624. [Google Scholar] [CrossRef] [PubMed]
- Carrasco, J.; Navarro, M.J.; Santos, M.; Dianez, F.; Gea, F.J. Incidence, identification and pathogenicity of Cladobotryum mycophilum, causal agent of cobweb disease on Agaricus bisporus mushroom crops in Spain. Ann. Appl. Biol. 2016, 168, 214–224. [Google Scholar] [CrossRef]
- García Cela, E.; Marín, S.; Reyes, M.; Sanchís, V.; Ramos, A.J. Conidial survival of Aspergillus section Nigri, Flavi and Circumdati under UV-A and UV-B radiation with cycling temperature/light regime. J. Sci. Food Agric. 2015, 96, 2249–2256. [Google Scholar] [CrossRef]
- Fourtouni, A.; Manetas, Y.; Christias, C. Effects of UV-B radiation in growth, pigmentation, and spore production in the phytopathogenic fungus Alternaria solani. Can. J. Bot. 1998, 76, 2093–2099. [Google Scholar] [CrossRef]
- Ignofo, C.M.; García, C. Influence of conidial color on inactivation of several entomogenous fungi by simulated sunlight. Environ. Entomol. 1992, 21, 913–917. [Google Scholar] [CrossRef]
- Atanasova, L.; Knox, B.P.; Kubicek, C.P.; Druzhinina, I.S.; Baker, S.E. The polyketide synthase gene pks4 of Trichoderma reesei provides pigmentation and stress resistance. Eukaryot. Cell 2013, 12, 1499–1508. [Google Scholar] [CrossRef]
- Wang, J.; Ma, Y.; Liu, Y.; Tong, S.; Zhu, S.; Jin, D.; Pei, Y.; Fan, Y. A polyketide synthase, BbpksP, contributes to conidial cell wall structure and UV tolerance in Beauveria bassiana. J. Invertebr. Pathol. 2020, 169, 107280. [Google Scholar] [CrossRef] [PubMed]
- Lai, C.; Chen, J.; Liu, J.; Tian, D.; Lan, D.; Liu, T.; Wu, B.; Bi, H.; Tang, J. New Polyketides from a Hydrothermal Vent Sediment Fungus Trichoderma sp. JWM29-10-1 and Their Antimicrobial Effects. Mar. Drugs 2022, 20, 720. [Google Scholar] [CrossRef] [PubMed]
- Li, X.; Huang, L.; He, Y.; Xie, C.; Zhan, F.; Zu, Y.; Sheng, J.; Li, Y. Effects of enhanced UV-B radiation on the interaction between rice and Magnaporthe oryzae in Yuanyang terrace. Photochem. Photobiol. Sci. 2019, 18, 2965–2976. [Google Scholar] [CrossRef] [PubMed]
- Kamweru, P.K.; Tindibale, E.L. Vitamin D and Vitamin D from Ultraviolet-Irradiated Mushrooms. Int. J. Med. Mushrooms 2016, 18, 205–214. [Google Scholar] [CrossRef] [PubMed]
- Torres, S.; González-Ramírez, M.; Gavilán, J.; Paz, C.; Palfner, G.; Arnold, N.; Fuentealba, J.; Becerra, J.; Pérez, C.; Cabrera-Pardo, J.R. Exposure to UV-B radiation leads to increased deposition of cell wall-associated xerocomic acid in cultures of Serpulla imantioides. Appl. Environ. Microbiol. 2019, 85, e00870-19. [Google Scholar] [CrossRef]
- Zhou, R.; Yang, H.; Lu, T.; Zhao, Y.; Zheng, W. Ultraviolet radiation promotes the production of hispidin polyphenols by medicinal mushroom Inonotus ubiquus. Fungal Biol. 2022, 126, 775–785. [Google Scholar] [CrossRef] [PubMed]
- Krsmanovic, N.; Raseta, M.; Miskovic, J.; Bekvalac, K.; Bogavac, M.; Karaman, M.; Isikhuemhen, O.S. Effects of UV Stress in promoting antioxidant activities in fungal species Trametes versicolor (L.) Lloyd and Flammulina velutipes (Curtis) Singer. Antioxidants 2023, 12, 302. [Google Scholar] [CrossRef]
- Szabo, A.; Gyepes, A.; Nagy, A.; Abranko, L.; Gyorfi, J. The effect of UVB radiation on the vitamin D2 content of white and cream type button mushrooms (Agaricus bisporus Lange/Imbach) and Oyster Mushrooms (Pleorotus ostreatus (Jacq.) P. Kumm). Acta Aliment. 2012, 41, 187–196. [Google Scholar] [CrossRef]
- Kristensen, H.L.; Rosenqvist, E.; Jakobsen, J. Increase of Vitamin D2 by UV-B exposure during the growth phase of white button mushroom (Agaricus bisporus). Food Nutr. Res. 2012, 56, 7114. [Google Scholar] [CrossRef]

| UV-B Dose (kJ m−2) | Culture Media | |||
|---|---|---|---|---|
| Cz | MEA | PDA | CT | |
| 0 | 100 | 100 | 100 | 100 |
| 8 | 80 | 80 | 100 | 100 |
| 24 | 20 | 20 | 80 | 80 |
| 48 | --- | --- | 20 | 60 |
| 96 | --- | --- | --- | 30 |
| 192 | --- | --- | --- | 20 |
Disclaimer/Publisher’s Note: The statements, opinions and data contained in all publications are solely those of the individual author(s) and contributor(s) and not of MDPI and/or the editor(s). MDPI and/or the editor(s) disclaim responsibility for any injury to people or property resulting from any ideas, methods, instructions or products referred to in the content. |
© 2024 by the authors. Licensee MDPI, Basel, Switzerland. This article is an open access article distributed under the terms and conditions of the Creative Commons Attribution (CC BY) license (https://creativecommons.org/licenses/by/4.0/).
Share and Cite
Hidalgo-Sanz, R.; Del-Castillo-Alonso, M.-Á.; Sanz, S.; Olarte, C.; Martínez-Abaigar, J.; Núñez-Olivera, E. The Two Mycological Sides of Ultraviolet-B Radiation: Harmless for Mushroom Mycelia, Harmful for Mycopathogenic Mould Spores. Agriculture 2024, 14, 681. https://doi.org/10.3390/agriculture14050681
Hidalgo-Sanz R, Del-Castillo-Alonso M-Á, Sanz S, Olarte C, Martínez-Abaigar J, Núñez-Olivera E. The Two Mycological Sides of Ultraviolet-B Radiation: Harmless for Mushroom Mycelia, Harmful for Mycopathogenic Mould Spores. Agriculture. 2024; 14(5):681. https://doi.org/10.3390/agriculture14050681
Chicago/Turabian StyleHidalgo-Sanz, Raquel, María-Ángeles Del-Castillo-Alonso, Susana Sanz, Carmen Olarte, Javier Martínez-Abaigar, and Encarnación Núñez-Olivera. 2024. "The Two Mycological Sides of Ultraviolet-B Radiation: Harmless for Mushroom Mycelia, Harmful for Mycopathogenic Mould Spores" Agriculture 14, no. 5: 681. https://doi.org/10.3390/agriculture14050681
APA StyleHidalgo-Sanz, R., Del-Castillo-Alonso, M.-Á., Sanz, S., Olarte, C., Martínez-Abaigar, J., & Núñez-Olivera, E. (2024). The Two Mycological Sides of Ultraviolet-B Radiation: Harmless for Mushroom Mycelia, Harmful for Mycopathogenic Mould Spores. Agriculture, 14(5), 681. https://doi.org/10.3390/agriculture14050681

